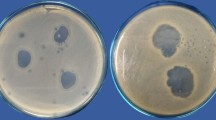

Abstract
DURING the war of 1914–18, W. S. Baer1, in the United States, noticed that when troops wounded in battle had been lying out on the ground unattended for some time, their wounds very commonly became infested with larvæ of certain kinds of flies. He noticed specially that when the wounds had acquired about their maximum maggot population they did not exhibit dangerous after-effects. On the other hand, men whose wounds had received prompt early treatment often developed infection. It was found that the presence of these larvæ was especially beneficial in cases of osteomyelitis. It was discovered that the larvæ were eating the necrotic tissue which was supporting the main bacterial infection, and at the same time these larvæ were inhibiting further bacterial growth. Stewart2 claimed that the scavenging larvæ play an important part in clearing the necrotic tissue, but that calcium carbonate, which is constantly excreted by the larvæ, is also important in alkalizing the medium (the wound) in which the bacteria live, and of increasing phagocytie activity.
This is a preview of subscription content, access via your institution
Access options
Subscribe to this journal
Receive 51 print issues and online access
$199.00 per year
only $3.90 per issue
Buy this article
- Purchase on SpringerLink
- Instant access to the full article PDF.
USD 39.95
Prices may be subject to local taxes which are calculated during checkout
Similar content being viewed by others
References
J. Bone and Joint Surjery, 13, 433 475 (1931).
Prelim. Rep. Surg. Gynaec. and Obst., 53, 155 105 (1934).
Ann. Trop. Med. and Paras., 28, 445 400 (1934).
U.S. Dept. of Agric, Bur. Entom. Ser. E., 311 (1933).
J. Amer. Med. Assoc., 98, 1143 49 (1932).
J. Econ. Ent., 30, 41 48 (1937).
Z. Kin. Insektenbiol., 27, 82 85 (1934).
Author information
Authors and Affiliations
Rights and permissions
About this article
Cite this article
IMMS, A. Dipterous Larvæ and Wound Treatment. Nature 144, 516–517 (1939). https://doi.org/10.1038/144516c0
Issue date:
DOI: https://doi.org/10.1038/144516c0